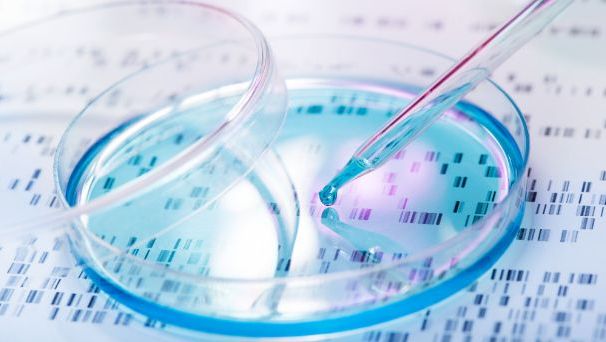
Panele genetyczne w kierunku nowotworów dziedzicznych Predict&Prevent - 138 genów

OFERTY NA KWIECIEŃ 2026
Dbaj o siebie i swoich bliskich z MediClub!
Dla Zdrowia Maluszka

-30% z MediClub!
Całogenomowy test prenatalny NIPT. Bada wszystkie 23 pary chromosomów i wyróżnia się wysoką skutecznością. Z bezpłatnym domowym pobraniem próbki

VERACITY jest jednym z najnowocześniejszych nieinwazyjnych badań prenatalnych (NIPT). To test nowej generacji, który pozwala na wykrycie zaburzeń chromosomowych płodu na wczesnym etapie ciąży.

-15% z MediClub!
VERAgene to pierwsze tak kompleksowe nieinwazyjne, przesiewowe badanie prenatalne (NIPT) pod kątem aneuploidii, mikrodelecji i mutacji punktowych.
Badanie VERAgene można wykonać już od 9. Tygodnia ciąży.
Dzień dla Zdrowia

Screening okołomenopauzalny to kompleksowa opieka diagnostyczna dla kobiet 40+, a nie tylko pojedyncze badania.

Badanie 2w1: kolonoskopia i gastroskopia w znieczuleniu - kompleksowa diagnostyka przewodu pokarmowego

Konsultacja ginekologiczna połączona z założeniem wkładki wewnątrzmacicznej (IUD). W trakcie wizyty lekarz przeprowadza wywiad medyczny, wykonuje badanie ginekologiczne oraz – w przypadku braku przeciwwskazań – zakłada wkładkę dostarczoną przez pacjentkę.

Profesjonalna diagnostyka bezdechu sennego w warunkach szpitalnych – z całonocnym monitoringiem i opieką zespołu pielęgniarskiego.

Badanie żołądka i przełyku – dokładnie, bezpiecznie i w pełnym komforcie.

Badanie żołądka i przełyku – dokładnie, bezpiecznie i w pełnym komforcie.

Badanie jelita grubego – sprawnie, bezpieczenie, bez stresu.

Badanie jelita grubego – sprawnie, bezpiecznie, bez stresu

Nowość
Zadbaj o zdrowie i bezpieczeństwo po 60-tce! Sprawdź swoją sprawność fizyczną, siłę i równowagę dzięki specjalistycznym testom i konsultacji z fizjoterapeutą. Odbierz indywidualny plan ćwiczeń i zyskaj większą pewność ruchu!

Zaawansowane, kompleksowe badanie molekularne w kierunku wirusa brodawczaka ludzkiego (HPV), przeznaczone dla mężczyzn od 18. roku życia. Umożliwia wykrycie 28 genotypów HPV, w tym typów wysokiego i niskiego ryzyka. Możliwość pobrania materiału samodzielnie lub przez personel medyczny.

Kompleksowa diagnostyka wirusa brodawczaka ludzkiego (HPV). Nowoczesny test molekularny wykrywający 28 genotypów wirusa HPV. Badanie dla kobiet od 18. r.ż.

Kwalifikacja do zabiegu biopsji fuzyjnej prostaty

-40% z MediClub!
Szczepienie przeciw HPV to forma profilaktyki, której celem jest zapobieganie zakażeniom wirusem brodawczaka ludzkiego (HPV) wywołującym m.in. raka szyjki macicy oraz inne nowotwory i brodawki płciowe. Szczepionka jest przeznaczona dla dzieci powyżej 9. roku życia oraz osób dorosłych i podawana jest w schemacie 3-dawkowym. Preparat 9-walentny chroni przed dziewięcioma typami wirusa HPV.

-40% z MediClub!
Pakiet szczepień przeciwko HPV (schemat 2-dawkowy) przeznaczony dla dzieci od 9. do 14. roku życia. Szczepionka jest przeznaczona do stosowania w zapobieganiu zakażenia wirusem HPV. Zakażenie określonymi typami HPV jest jedną z przyczyn m.in. raka szyjki macicy, brodawek płciowych (kłykcin kończystych) i krtani.

Konsultacja z obesitologiem (wizyta pierwszorazowa) to spotkanie ze specjalistą, który pomoże Ci zrozumieć przyczyny nadwagi i zaproponuje skuteczne metody jej redukcji. Podczas wizyty otrzymasz indywidualny plan leczenia, dopasowany do Twojego stylu życia i potrzeb zdrowotnych. Postaw na zdrowie i zacznij swoją drogę do lepszej jakości życia!


Pakiet zawiera w sobie test Colotect wraz z konsultacja internisty. Colotect to prosty, szybki i bezpieczny test epigenetyczny, który wykrywa zmiany nowotworowe w jelicie grubym.

Do -25% z MediClub!
Cytologia płynna LBC wykrywa ok. 64% więcej zmian wysokiego ryzyka niż tradycyjne badanie cytologiczne. Rozszerzenie badania o test na obecność 28 typów HPV pozwala na wczesne wykrycie i identyfikację konkretnego typu wirusa, który może prowadzić do rozwoju raka szyjki macicy. Jest to kluczowe w ocenie ryzyka nowotworu i daje szanse na całkowite wyleczenie.

-20% z MediClub!
Pakiet podstawowy z konsultacją fizjoterapeutyczną.



-5% z MediClub
Na Twojej skórze pojawiła się niepokojąca zmiana? Albo przybył Ci do kolekcji nowy pieprzyk? Masz od dawna znamię nigdy niebadane? Skorzystaj z pakietu, dzięki któremu dermatolog przy użyciu wideodermatoskopu kompleksowo oceni zmiany na skórze.

Wideodermatoskopia całego ciała to nowoczesne, nieinwazyjne badanie, które umożliwia dokładną ocenę znamion skórnych na całym ciele pacjenta, zarówno tych widocznych, jak i ukrytych.

Fizjoterapia na wielu płaszczyznach, dopasowana do potrzeb pacjenta, wspomagająca powrót do sprawności.

Badanie przeznaczone jest dla osób pełnoletnich, chcących sprawdzić swoje ryzyko genetyczne w kierunku nowotworów dziedzicznych i świadomie dbać o swoje zdrowie.

Szczepienie przeciwko HPV to forma profilaktyki, której celem jest zapobieganie zakażeniom wirusem brodawczaka ludzkiego (HPV), odpowiedzialnym m.in. za raka szyjki macicy i brodawki płciowe. Szczepionka przeznaczona jest dla dzieci od 9. roku życia oraz osób dorosłych. Schemat szczepienia obejmuje 2 lub 3 dawki, w zależności od wieku i historii szczepień.


Czas na Trening

Karta sportowa Well Fitness to karnet umożliwia dostęp do ponad 90 klubów Well Fitness na terenie Polski, obejmujących m.in.siłownie, zajęcia fitness oraz zajęcia grupowe. Karta pozwala na regularną aktywność fizyczną przez okres 12 miesięcy.

Karta sportowa CityFit to karnet umożliwiający dostęp do klubów fitness CityFit na terenie Polski, oferujących nowoczesne siłownie oraz zajęcia fitness. Karnet pozwala na regularną aktywność fizyczną przez okres 12 miesięcy.

Karta sportowa CityFit to karnet umożliwiający dostęp do klubów fitness CityFit na terenie Polski, oferujących nowoczesne siłownie oraz zajęcia fitness. Karnet pozwala na regularną aktywność fizyczną przez okres 6 miesięcy.

Karta sportowa Well Fitness to karnet umożliwia dostęp do jednego z ponad 90 klubów Well Fitness na terenie Polski, obejmujących m.in.siłownie, zajęcia fitness oraz zajęcia grupowe. Karta pozwala na regularną aktywność fizyczną przez okres 6 miesięcy.

Serce pod Kontrolą

Ventrilla to szybkie badanie genetyczne, które wykrywa wrodzone ryzyko chorób sercowo-naczyniowych. Analizuje 292 geny i pomaga wcześnie wykryć zagrożenia takie jak arytmie czy kardiomiopatie. Wynik otrzymasz w 3–5 tygodni, a w cenie jest bezpłatna konsultacja z genetykiem.

Ventrilla to badanie genetyczne, które wykrywa zmiany w genach związanych z chorobami układu sercowo-naczyniowego. Jest dostępnych 7 różnych paneli nakierunkowanych na wykrywanie takich schorzeń jak: arytmia, aortopatia, kardiomiopatia , hipercholesterolemia rodzinna, RASopatia, nadciśnienie płucne oraz panel poświęcony diagnostyce wrodzonych wad serca.

Kompleksowa diagnostyka układu krążenia, która pozwala wykryć lub wykluczyć najczęstsze schorzenia kardiologiczne.




Rytuał Uśmiechu

Regularnie wykonywany przegląd stomatologiczny pomoże Ci kontrolować stan zdrowia jamy ustnej. Zapobiegaj chorobom i umów się na wizyte u stomatologa.

Podczas konsultacji protetycznej lekarz pomoże Ci w dobraniu idealnego planu leczenia estetyki Twojego uśmiechu.

Do -62% z MediClub!
Podczas konsultacji ortodontycznej lekarz oceni stan zebów oraz zgryz pacjenta. Zaproponuje plan leczenia wady zgryzu oraz przedstawi koszty leczenia.

Wybiel swoje zęby i skorzystaj z pomocy specjalistów. Wybielanie przeprowadzane jest przez stomatologa w placówce Medicover.
Rozkwitaj na Wiosnę

Laser Nd:Yag to skuteczna metoda usuwania widocznych naczyń krwionośnych na policzkach. Dzięki temu zabiegowi Twoja skóra odzyska jednolity koloryt i promienny wygląd – poczuj się pewniej każdego dnia!

Czy marzysz o gładkiej i młodzieńczej skórze bez zmarszczek? Nasza usługa z wykorzystaniem toksyny botulinowej jest idealnym rozwiązaniem dla osób pragnących pozbyć się oznak starzenia na czole i wokół oczu. Dzięki niej możesz znowu cieszyć się promiennym i świeżym wyglądem!






-40% z MediClub!
Ochrona przed KZM

-20% z MediClub
Pojedyncza dawka szczepienia przeciw kleszczowemu zapaleniu mózgu (KZM) dla dzieci

-20% z MediClub
Pojedyncza dawka szczepienia przeciw kleszczowemu zapaleniu mózgu dla osób od 16. r.ż.


Pakiet szczepień przeciw kleszczowemu zapaleniu mózgu obejmuje pełny podstawowy cykl szczepienia składający się z 3 dawek szczepionki oraz wizyt kwalifikacyjnych. Szczepienie ma na celu ochronę przed kleszczowym zapaleniem mózgu. Pakiet przeznaczony jest dla osób od 16. roku życia.


Czy to Alergia?

ALEX3 to kompleksowy test alergii IgE-zależnej, który pomaga szczegółowo poznać reakcje organizmu na alergeny wziewne, pokarmowe i inne. Analizuje 300 alergenów, w tym 107 unikalnych komponentów dostępnych wyłącznie w tym panelu, zapewniając pełny i przejrzysty obraz profilu alergicznego.

Testy kontaktowe płatkowe to badanie, które pozwala sprawdzić, czy Twoja skóra reaguje alergicznie na wybrane substancje (alergeny kontaktowe).


Badanie jest idealne dla dzieci i dorosłych z alergią pokarmową i wziewną.Test Alex 2 to najszerszy panel alergiczny. 295 alergenów (178 molekuł i 117 ekstraktów).



-20% z kodem ALERGIA20
Pakiet badań krwi z oznaczeniem puli alergenów.

Wsparcie od Środka

2 za 1
Omega-3 Medicover Vital to suplement diety przeznaczony dla osób dorosłych, które chcą uzupełnić codzienną dietę w długołańcuchowe kwasy tłuszczowe omega-3. Zawiera kwasy EPA i DHA w postaci naturalnych trójglicerydów oraz witaminę E. EPA i DHA przyczyniają się do prawidłowego funkcjonowania serca*, natomiast DHA pomaga w utrzymaniu prawidłowego funkcjonowania mózgu** oraz prawidłowego widzenia**.
* Korzystne działanie występuje przy spożyciu 250 mg EPA i DHA dziennie.
** Korzystne działanie występuje przy spożyciu 250 mg DHA dziennie.

2 za 1
Medicover Vital Maślan Sodu to środek spożywczy specjalnego przeznaczenia medycznego, który korzystnie wpływa na działanie przewodu pokarmowego.

2 za 1

2 za 1

2 za 1
Suplement diety wspiera w utrzymywaniu zdrowej wątroby, ułatwia rozpuszczanie się cholesterolu w przewodach żółciowych.